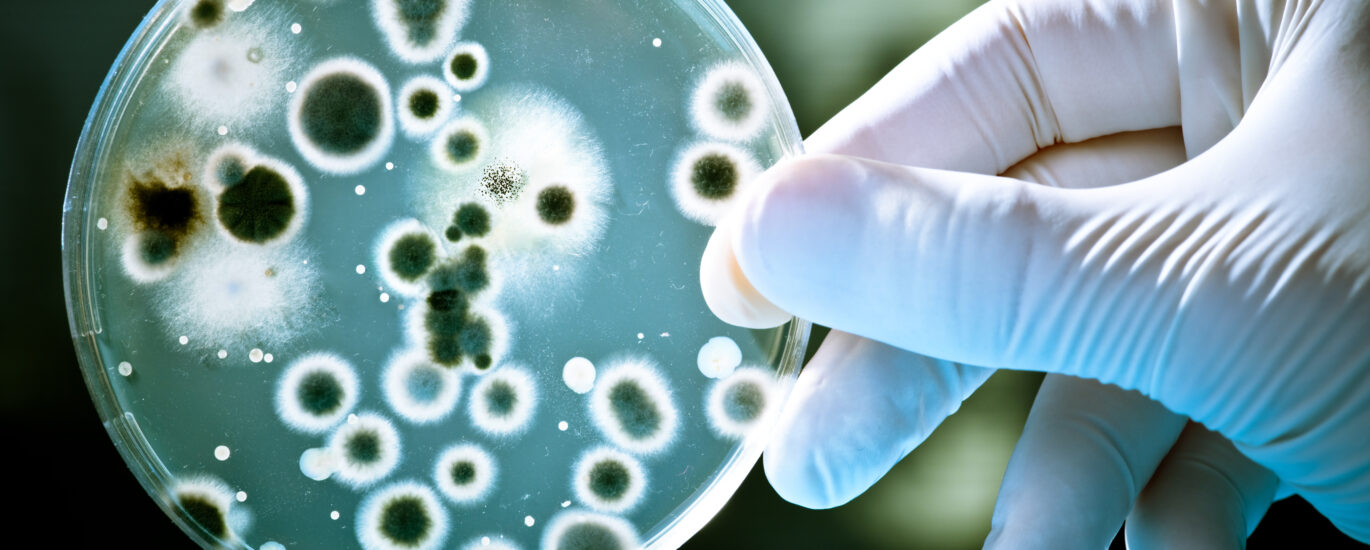

Microbial Food Culture Market was projected to reach a valuation of US$ 1.9 Bn in 2022 and expected to reach at US$ 3.5 Bn in 2032, likely to surge at a vigorous 6.1% CAGR during Forecast 2022 – 2032.
Microbial food cultures are a group of microorganisms such as bacteria, fungi, and mold used in the food and beverage industry for processing food items. They are often used to preserve food, improve and enhance the nutritional value, so it does not depreciate.
Times before now, fermentation has been a food preservation process practiced worldwide. Fermented food products have been part of humans’ regular diet. There are many health benefits attributed to fermentation as a food preservation process, and this has fostered the rise in demand for food products or items preserved through it.
Request our Sample report on the Microbial Food Culture Market and stay informed about industry trends and forecasts! https://www.futuremarketinsights.com/reports/sample/rep-gb-837
The microorganisms used in food cultures often impart acidity, flavour, and texture to final food products. While the organisms are present in food naturally, they can also be added artificially as a starter culture in industrial food processing.
Growing demand for natural products, rising disposable income, and the increasing number of working women are major factors driving the growth of the global microbial food culture industry. Other factors, like increasing consumers’ awareness regarding the health benefits associated with the consumption of natural products, is another growth driver expected to drive the microbial food cultures market forward over the forecast period.
Microbial Food Cultures Market Growth Driven by Increasing Demand for Starter Cultures
Over the years, there has been substantial growth in the consumption of fermented food products due to their valuable traits such as the extension of shelf life, preservation, and sensory quality. These attributes have fostered the rise in demand for microbial food cultures industry, and this is expected to continue over the forecast period.
However, fermented food products are manufactured using the starter cultures process for specific and expectable fermentation. Starters such as yeast and Lactic Acid Bacteria (LAB) are the highly studied starters used in various fermented food product production process.
Growing Consumer Demand for Healthy Food Products
With the rise in awareness regarding the health benefits associated with the consumption of fermented food products, there has been a surge in demand for microbial food cultures globally. Consumers are on the rise for healthy food products such as functional food and probiotic food supplements.
This surge in consumers’ demand has fostered the increase in demand for microbial food cultures, and this is expected to continue over the forecast period. In addition, manufacturers are switching towards the production of new food products with value addition of
Microbial Food Cultures Market: Competitive Landscape
- AECI Limited
- CSK Food Enrichment
- Cargill Incorporated
- Chr. Hansen A/S
- Lactina Ltd.
- Koninklijke DSM N.V.
- Frutarom
- The TATUA Co-operative Dairy Company Ltd
- Vitakem Nutraceutical In.
Microbial Food Culture Market by Category
By Product Type:
- Probiotics Culture
- Starter Cultures
- Adjunct and Aroma Cultures
By Microorganism Type:
- Bacteria
- Mold
- Yeast
By Function:
- Flavoring Agent
- Texturizing Agent
- Preservative Agent
- Coloring Agent
- Nutritional Agent
- Other Functions
By End-Use Industry:
- Dairy Industry
- Beverages
- Bakery and Confectionery Industry
- Fruits and Vegetable Industry
- Other Industries
Unlock the secrets of the Microbial Food Culture Market! Purchase now and delve into the intricacies of each segment. https://www.futuremarketinsights.com/checkout/837
Frequently Asked Questions
- What is the demand outlook for the microbial food culture market currently?
- At what growth rate is the microbial food culture market expanding?
- How much is the microbial food culture market expected to be valued at over the forecast period?
- Where is the microbial food culture market expected to expand in the coming years?
- Who are the key players in the microbial food culture market?
About Future Market Insights (FMI)
Future Market Insights, Inc. (ESOMAR certified, recipient of the Stevie Award, and a member of the Greater New York Chamber of Commerce) offers profound insights into the driving factors that are boosting demand in the market. FMI stands as the leading global provider of market intelligence, advisory services, consulting, and events for the Packaging, Food and Beverage, Consumer Technology, Healthcare, Industrial, and Chemicals markets. With a vast team of over 5000 analysts worldwide, FMI provides global, regional, and local expertise on diverse domains and industry trends across more than 110 countries.
Contact Us:
Future Market Insights Inc.
Christiana Corporate, 200 Continental Drive,
Suite 401, Newark, Delaware – 19713, USA
T: +1-845-579-5705
For Sales Enquiries: sales@futuremarketinsights.com
Website: https://www.futuremarketinsights.com
LinkedIn| Twitter| Blogs | YouTube